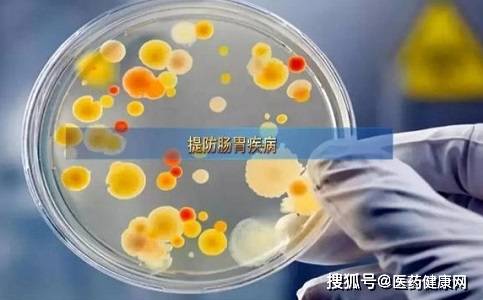

日前,人體會隨著氣候的變化而改變,甚至出現一些因燥、寒誘發的不適症狀。在養生健體、合理飲食、生活作息方面該注意些什麼?來聽聽專家的提醒與建議。
小心呼吸道疾病
醫生提醒,有呼吸系統疾病的老年人更應注意,因為老年人呼吸系統防禦能力本來就弱,加上氣溫變化,很容易導致慢性氣管炎等的復發。秋季各種過敏原也開始增多,因此過敏體質的人應避免與過敏原接觸。
提防腸胃疾病
秋季也是腸胃疾病的高發季節,痢疾桿菌、傷寒桿菌、沙門氏菌、副溶血性弧菌等都是常見的病原菌,稍有不慎就可能發生腹瀉。由於氣候轉涼,人們的食慾隨之旺盛,使腸胃功能的負擔加重,也會導致胃病復發。
預防「秋病」
時熱時涼的天氣,讓「秋病」隨之而來。本身有基礎病、慢性病的人群在這一時期要注意防「秋病」。氣溫波動,血管的收縮和擴張力度也會增大,容易導致急性冠脈綜合征、腦梗等多種與血管健康有關的疾病。
作筆記是好習慣,給你新想法